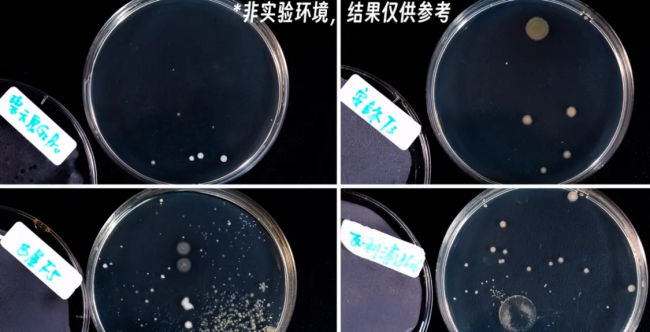

凈水器哪家好!碧云泉、安吉爾、西屋、飛利浦品牌大測評

如果家庭人數(shù)比較多,用水量比較大的話,廚下式凈水器挺方便但只能在廚房使用,索然是不夠便捷。但是如果是3-5口家庭,或者像工作室、老小區(qū)這種壓根兒沒有水路的環(huán)境,臺式凈水器無疑性價比更高,搬家也方便帶走!

測評者一共準備了4臺凈水器,剛好均勻覆蓋了2000-4000價位段。本期為橫評內(nèi)容,方便大家參考一下,到底哪個價位的凈水器更適合消費者。
凈化效果對比
凈水器最重要的就是凈化效果,所以先從凈水能力來對比。4款凈水器,只有飛利浦面板上完全沒有TDS顯示,安吉爾只能顯示出水的TDS。


碧云泉凈水器和西屋凈水器都能顯示凈水的TDS。可能有消費者還不知道TDS是什么意思,這里簡單科普一下:它表示1L水中有多少mg的溶解性固體,TDS越高說明雜質(zhì)就越多,水就越硬。
市政自來水的TDS一般在100左右,像湖北最高能到400的,算很硬的。燒開水對降低TDS沒啥用,長期飲用這種高硬度的水,無疑會增加結(jié)石風險。

作為參考,瓶裝礦泉水的TDS在40左右,純凈水就是個位數(shù)。當然這些可溶固形物也不要一竿子打死,畢竟對人體有益的一些礦物元素也會被算在里面,只要符合國家標準50以下就OK。

雖然它們面板上顯示的凈水TDS值都很低,但是由于這4臺凈水器都有“礦化”功能,都會在濾芯里加入“鍶”之類的礦物元素,提升營養(yǎng)和口感,所以實際出水的TDS值都會高一些。
在測試之后,發(fā)現(xiàn)4款凈水器的出水TDS值差不多,都在10左右,凈化效果都是非常不錯的。
凈水速度對比

4款產(chǎn)品的凈水速度區(qū)別挺大的。如果同時開始制水,碧云泉G3Pro希爾能夠最快把水壺灌滿,其次是飛利浦8606和西屋F5。
抑菌能力對比
除了TDS,凈水器的抑菌能力也同樣值得關(guān)注,畢竟都是儲水設(shè)計,凈水存在過夜的情況,抑菌能力就很重要。
4款凈水器,水路和水壺都采用了抑菌材料。那除了被動抑菌,碧云泉G3希爾凈水器和飛利浦8606還有主動殺菌設(shè)計。不過飛利浦的紫外燈設(shè)計在冰膽里,所以只有冰水能享受到紫外殺菌。
而碧云泉凈水器則是直接給儲水壺殺菌,不管是溫水還是冷水,都能享受到這個殺菌服務(wù),所以碧云泉凈水器理論上抑菌效果是幾款中最好的。
為了嚴謹一點,測評者也做了一個測試,讓凈水在機器上放置一夜,第二天把它們滴到R2A培養(yǎng)基上,恒溫培養(yǎng)個3天。
從菌落生長的情況來看,碧云泉凈水器的整體表現(xiàn)確實更好一些,隔夜水的細菌最少。如果家里有小寶寶,早上需要沖泡奶粉的話,建議選擇這種主動殺菌設(shè)計的產(chǎn)品。
使用成本對比

除了水質(zhì)和用水安全,消費者最關(guān)心的就是使用成本,畢竟凈水器不是一次性投資的家電產(chǎn)品,后期的使用成本也是開支的大頭。4款產(chǎn)品的換芯成本基本和售價成正比。雖然西屋、飛利浦和安吉爾的濾芯數(shù)量少一些,但是其實它們本質(zhì)還是傳統(tǒng)的三級濾水設(shè)計,只是把一級過濾和三級過濾復合到了一個濾芯里。雖然可以少換個濾芯省點事,但是可能會導致1級濾芯消耗完了,3級濾芯還有壽命,但是必須得整體更換的浪費問題。

碧云泉凈水器還是堅持使用了三只分開設(shè)計,每只過濾各司其職,濾芯能用到壽命完全結(jié)束,所以過濾水量相對更大,使用壽命也更加彈性一些。
附加功能對比

其實消費者單看這些凈水器最核心的是凈水功能,安吉爾、碧云泉這2款低價機型其實和飛利浦、西屋這兩款高價機型沒有什么特別大的差別,凈水成本整體還更低一點。真正拉開它們價格差距的還是在附加功能上。飛利浦、西屋除了能制熱水外,還能制冷水、制冰。不過消費者體驗下來差強人意。

冰水機主要有噪音問題,壓縮機工作時噪音都50db以上。西屋相對好一點,差不多工作半個小時就停了,不過相對的,制冷溫度只能到10℃。
飛利浦凈水器雖然能制冷到5℃,但是制冷時間是非常的長,初次制冷差不多兩個小時。如果環(huán)境溫度只有十來度,換到夏天話時間會更長。若是工作室沒有獨立水間的開放環(huán)境,長時間的噪音,確實難以接受。

所以這制冷的兩臺機型其實并不適合家用,畢竟差價完全夠買臺冰箱,制冰效率更高,也沒大的噪音。
最后點評
最后點評這4臺機型,方便大家選購參考。
第一推薦的是碧云泉G3Pro希爾凈水器:不管是定價還是使用成本,都是這幾款中性價比很高的。更加嚴格的抑菌設(shè)計,非常適合家里有娃的家庭。很多消費者以為它沒有童鎖,因為面板上看不到童鎖按鈕,其實它是有童鎖功能的,長按60ml水量按鈕就能開關(guān)童鎖。還有一點,有些消費者的餐邊柜是靠墻的,縱深30CM左右,碧云泉G3希爾深度26CM而且它的水箱設(shè)計在側(cè)面,也不用擔心提起來的時候會刮墻壁。消費者若是存在這樣的困擾,這款是強烈推薦的。
第二推薦安吉爾T3凈水器:價格最便宜,不過相對的制水速度最慢,加上沒有童鎖功能,更適合家里沒有娃,獨居或者兩人的小型家庭。

評測來源:B站 PPimy皮米
網(wǎng)友評論
評測排行
延伸閱讀
- 進口凈水器品牌哪個值得購買德國洛恩斯更專業(yè)
- 母嬰富鍶凈水器,貝諾特只為寶寶飲水健康而面市
- 國際知名凈水器高端進口凈水品牌菲浦斯引領(lǐng)行業(yè)風暴
- 全屋中央凈水器到底有什么用?立升凈水帶你揭曉
- 顏值高 流量大 3秒接滿一杯 小純Netpure800G大通量凈水器
- 立升嬰愛凈水器C5,父母的放心選擇,寶寶的健康飲水小衛(wèi)士
- 水龍頭式凈水器值得買嗎?消協(xié)一場比對試驗揭示真相
- vivo首家5G體驗專區(qū)在上海揭牌,5G現(xiàn)場測速比4G快二十倍
- 揭開神秘面紗 媒體走進國家首個智能家居質(zhì)量監(jiān)督檢驗中心
- 電競的魅力紅魔3帶你感受 史上最強電競手機你知道嗎?

京公網(wǎng)安備:11010602130026號